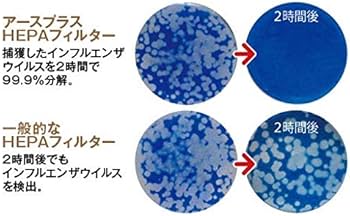
Amazon | L&AIR LEDシーリングライト付天井設置型空気清浄機 SEC-ACL02

割引発見 空気清浄付きLED証明 SEC-ACL 02 Amazon | L&AIR LEDシーリングライト付天井設置型空気清浄機 SEC-ACL02 スピーカー・ウーファー
(3010件)
Pontaパス特典
サンキュー配送
18150円(税込)
182ポイント(1%)
Pontaパス会員ならさらに+1%ポイント還元!
送料
(
)
3002
配送情報
お届け予定日:2026.04.15 16:16までにお届け
※一部地域・離島につきましては、表示のお届け予定日期間内にお届けできない場合があります。
ロットナンバー
64512121070
お買い物の前にチェック!

Pontaパス会員なら
ポイント+1%
ポイント+1%
商品説明
空気清浄付きLED証明 SEC-ACL 02照明器具に空気清浄機能が付いている品物です。中古品ですのでご理解頂ける方のみご購入お願い致します。参考価格¥264,000特許技術earthplusをして作られた空気清浄機除菌・脱臭・集じん菌・ウイルス・花粉・アレルゲン物質を吸着し分解します新型コロナ、インフルエンザなどのウイルスも不活化させることが実証されています。消臭能力にも優れています。天井設置で照明も兼ねているのでスペースもとりません。品 番:SEC-ACL 02設 置:天井設置サイズ:664mm*664mm*200mm重 量:約9.5kg(フィルター装着時)風 量:4.2㎥/5.1㎥(50Hz/60Hz)※ターボ運転時■お部屋の広さ約14畳まで適用(集じん性能において)■リモコン付属■3段階の風量設定(標準・急速・ターボ)■照明は20段階の調光土日祝は出荷が出来ませんご了承下さい| カテゴリー: | テレビ・オーディオ・カメラ>>>スピーカー・ウーファー>>>スピーカー |
|---|---|
| 商品の状態: | やや傷や汚れあり","目につく傷や汚れがある |
| 配送料の負担: | 送料込み(出品者負担) |
| 配送の方法: | クロネコヤマト |
| 発送元の地域: | 埼玉県 |
| 発送までの日数: | 4~7日で発送 |
レビュー
商品の評価:




 5.0点(3010件)
5.0点(3010件)
- ライ1122
- ボイルして食べましたが、味がしっかりしていて美味しかったです。 調理法がどこにも書いてなかったので、ホームページで確認したのが面倒でした。
- sk0175
- 見た目がテンションがあがりますよね。友人宅にお土産で持って行ったので、盛り上がりました。みんなんで切り分けて食べるので、ワイワイします。ピリッとしてビールとよく合いました。
- mちゃん_
- 冷凍便で届くので、食べる分だけ冷凍庫で解凍して食べてます。沖縄からなので、どうしても送料がかかるけど、比較的安かった。 良い買い物でした。
- けんぼー4638
- チョリソはこのチョリソが一番美味しいです。 焼き方のレシピも付いてたので親切でした。 リピ確定です。
- hirokun9574
- 主人が、この激辛チョリソーにハマり 思い切って5kg購入しました 主人はお酒のつまみに、私はご飯のおかずに パリッと本当に美味しいチョリソーです スーパーセール中に注文したにもかかわらず 発送も早くて嬉しいです ありがとうございます!
すべて見る
お店の情報
7,367
連絡・応対
4.3
配送スピード
4.3
梱包
4.3